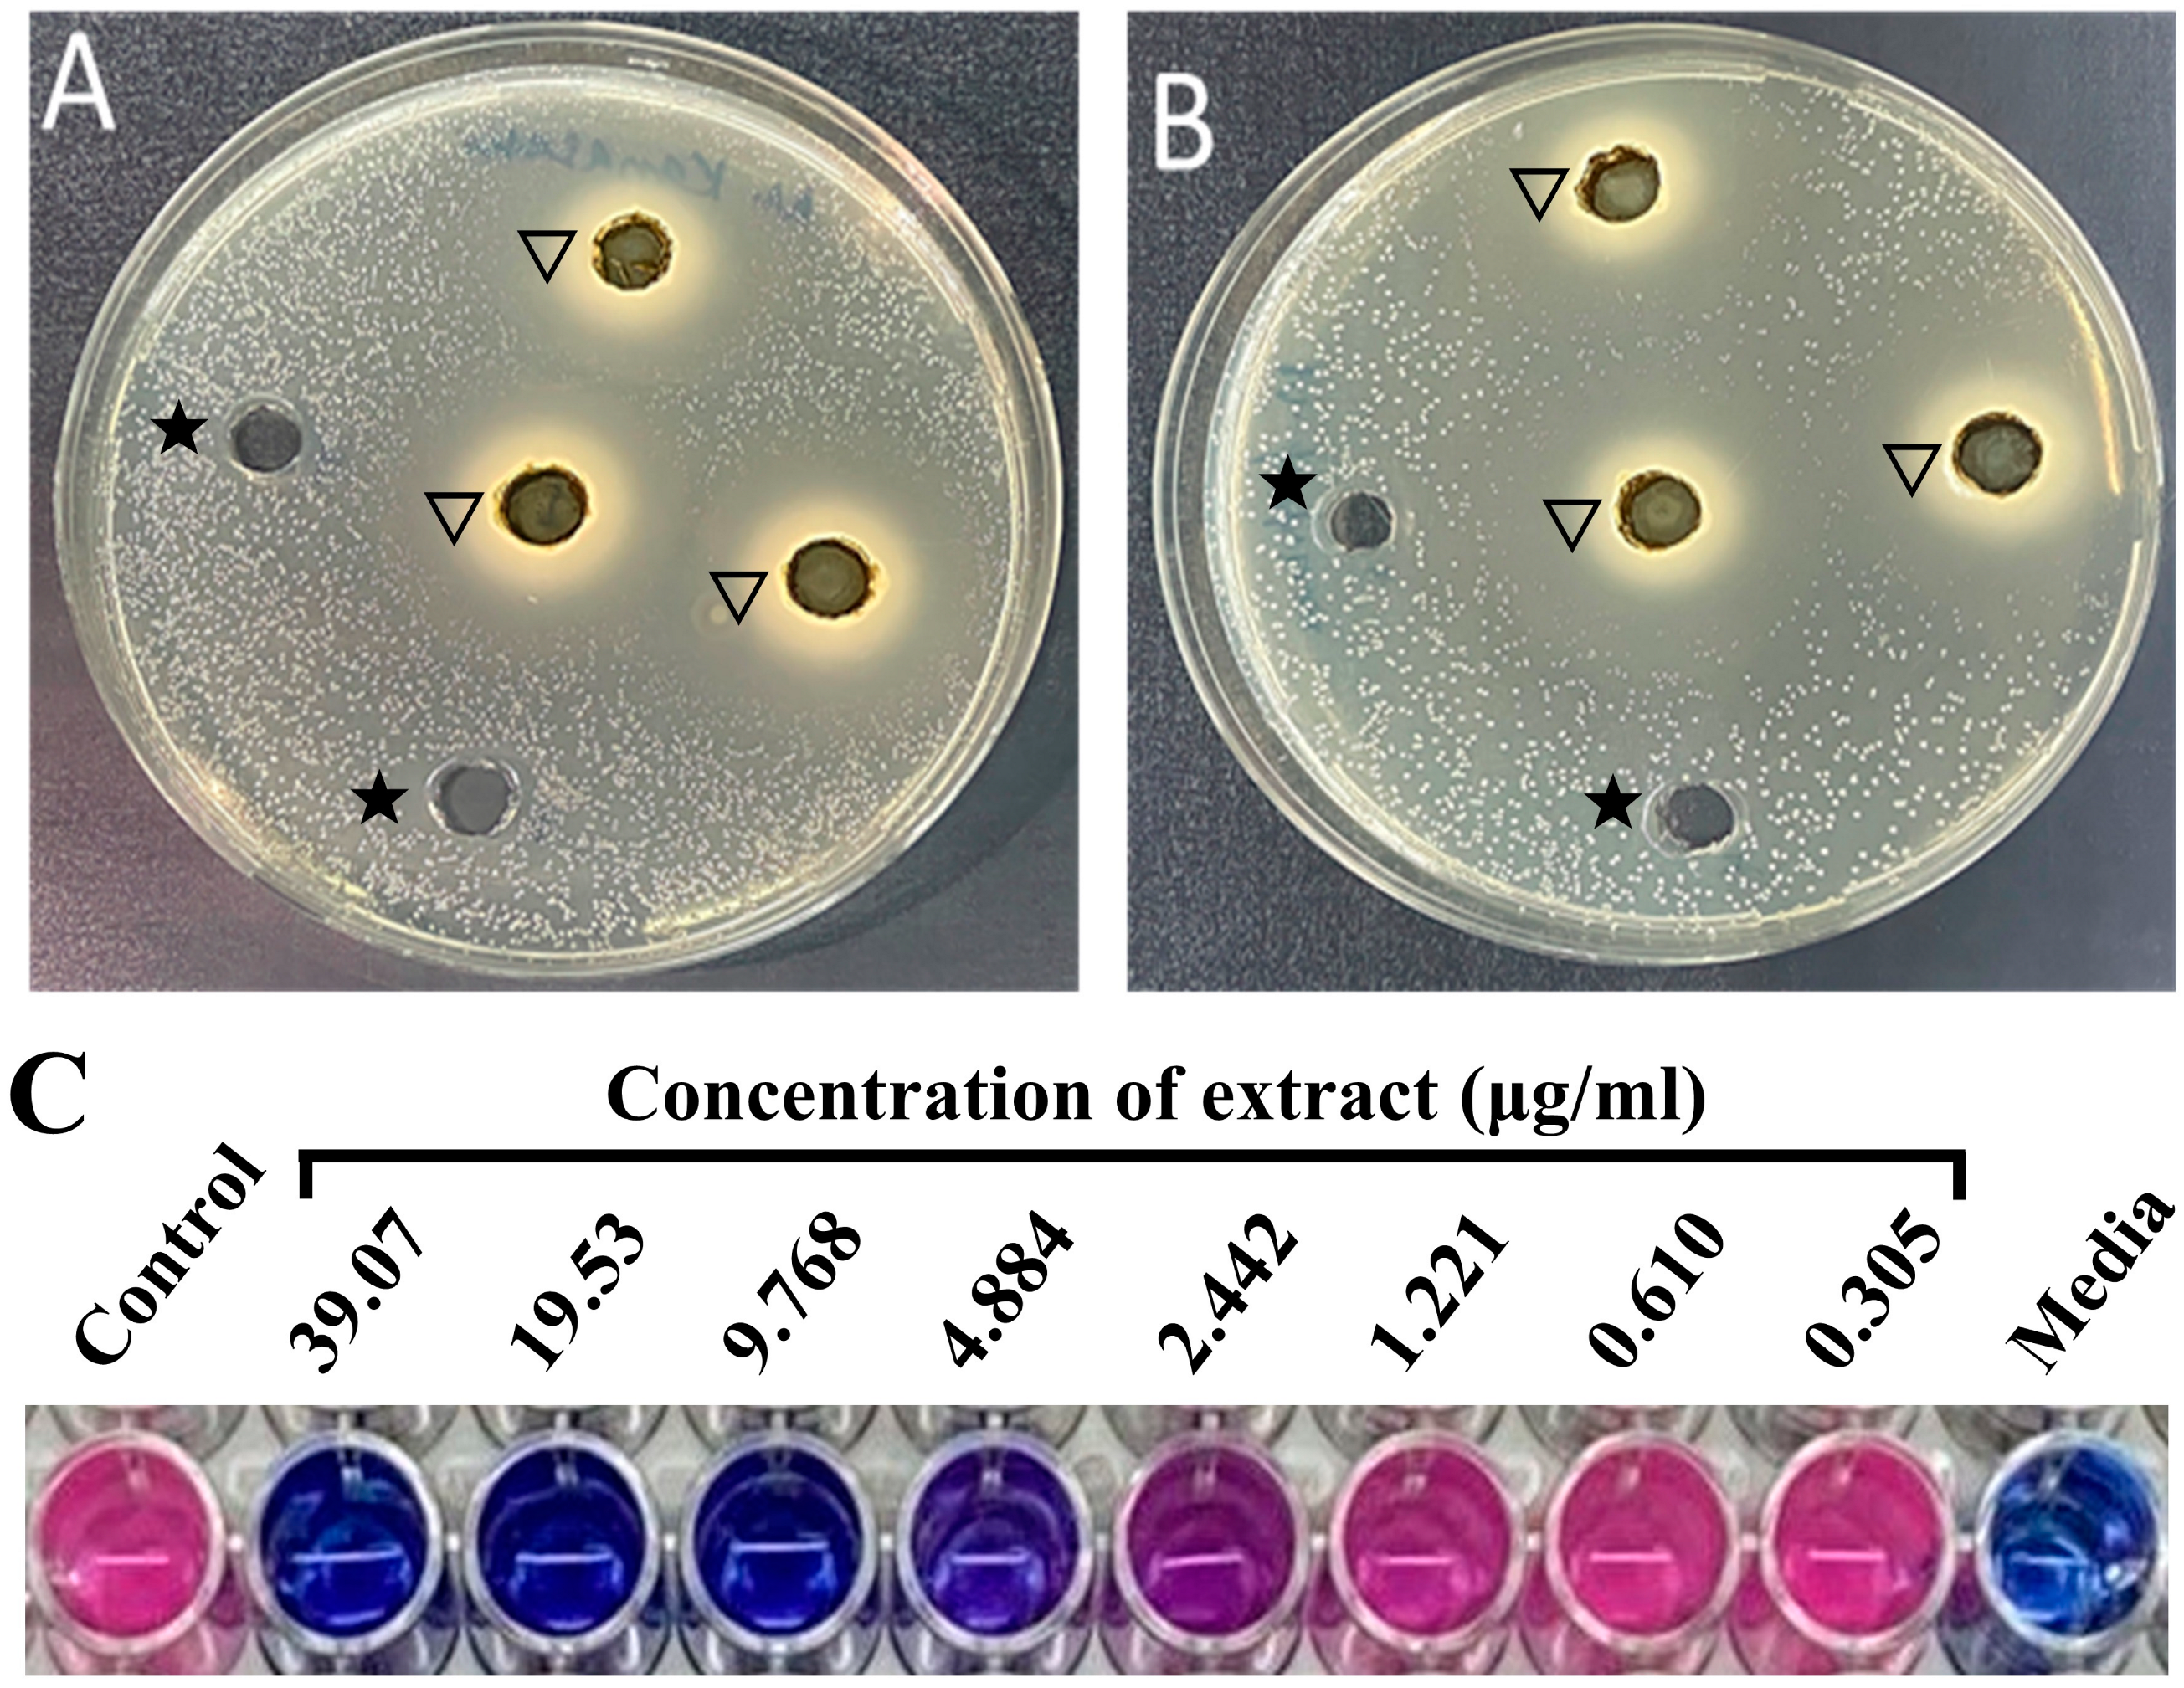
Pharmaceuticals 17 00872 g001

Antimycobacterial and Anticancer Properties of Myrtus communis Leaf Extract
Abstract
1. Introduction
2. Results
2.1. M. communis Leaf Extract Strongly Inhibited the Growth of Mycobacterial Strains
2.2. Growth Kinetics of the Bacterial Strains in the Presence of the Extract
2.3. M. Communis Leaf Extract Damages the Bacterial Cell Wall
2.4. M. communis Leaf Extract Inhibits the Biofilm Formation of M. smegmatis and S. aureus
2.5. M. communis Leaf Extract Inhibited the Proliferation of Cancer Cell Lines
2.6. M. communis Leaf Extract Caused Cell Cycle Arrest and the Induction of Apoptosis in Cancer Cells
3. Discussion
4. Materials and Methods
4.1. Preparation of Plant Extract
4.2. Bacterial Strains and Media
4.3. Zone of Inhibition
4.4. Minimum Inhibitory Concentration (MIC)
4.5. Minimum Bactericidal Concentration
4.6. Microplate AlamarBlue Assay (MABA)
4.7. Crystal Violet Biofilm Assay
4.8. Transmission Electron Microscopy (TEM)
4.9. Cell Culture
4.10. Cytotoxicity Assessment
4.11. Assessment of Cell Cycle Distribution Using DNA Flow Cytometry
4.12. Apoptosis Analysis
4.13. Statistical Analysis
5. Conclusions
Supplementary Materials
Author Contributions
Funding
Institutional Review Board Statement
Informed Consent Statement
Data Availability Statement
Conflicts of Interest
Abbreviations
| Hepatocellular carcinoma (HCC). |
| Extracellular polymeric substances (EPSs). |
| Non-tuberculosis mycobacteria (NTM). |
| Minimum inhibitory concentration (MIC). |
| Minimum bactericidal concentration (MBC). |
| Minimum biofilm inhibitory concentration (MBIC). |
| Minimum biofilm eradication concentration (MBEC). |
References
- Aleksic, V.; Knezevic, P. Antimicrobial and antioxidative activity of extracts and essential oils of Myrtus communis L. Microbiol. Res. 2014, 169, 240–254. [Google Scholar] [CrossRef] [PubMed]
- Mohamed, M.E.; Mohafez, O.M.; Khalil, H.E.; Alhaider, I.A. Essential Oil from Myrtle Leaves Growing in the Eastern Part of Saudi Arabia: Components, Anti-inflammatory and Cytotoxic Activities. J. Essent. Oil Bear. Plants 2019, 22, 877–892. [Google Scholar] [CrossRef]
- Al-Snafi, A.E.; Teibo, J.O.; Shaheen, H.M.; Akinfe, O.A.; Teibo, T.K.A.; Emieseimokumo, N.; Elfiky, M.M.; Al-kuraishy, H.M.; Al-Garbeeb, A.I.; Alexiou, A.; et al. The therapeutic value of Myrtus communis L.: An updated review. Naunyn. Schmiedebergs Arch. Pharmacol. 2024, 397, 4579–4600. [Google Scholar] [CrossRef] [PubMed]
- Amensour, M.; Sendra, E.; Abrini, J.; Bouhdid, S.; Pérez-Alvarez, J.A.; Fernández-López, J. Total Phenolic Content and Antioxidant Activity of Myrtle (Myrtus communis) Extracts. Nat. Prod. Commun. 2009, 4, 1934578X0900400. [Google Scholar] [CrossRef]
- Hosseinzadeh, H.; Khoshdel, M.; Ghorbani, M. Antinociceptive, Anti-inflammatory Effects and Acute Toxicity of Aqueous and Ethanolic Extracts of Myrtus communis L. Aerial Parts in Mice. J. Acupunct. Meridian Stud. 2011, 4, 242–247. [Google Scholar] [CrossRef] [PubMed]
- Nassar, M.; Aboutabl, E.-S.; Ahmed, R.; El-Khrisy, E.-D.; Ibrahim, K.; Sleem, A. Secondary metabolites and bioactivities of Myrtus communis. Pharmacogn. Res. 2010, 2, 325. [Google Scholar] [CrossRef]
- Mir, M. Myrtus communis leaves:source of bio-actives, traditional use, their biological properties, and prospects. Boletin Latinoam. Caribe Plantas Med. Aromat. 2024, 23, 487–515. [Google Scholar] [CrossRef]
- Khawbung, J.L.; Nath, D.; Chakraborty, S. Drug resistant Tuberculosis: A review. Comp. Immunol. Microbiol. Infect. Dis. 2021, 74, 101574. [Google Scholar] [CrossRef]
- Rather, M.A.; Gupta, K.; Mandal, M. Microbial biofilm: Formation, architecture, antibiotic resistance, and control strategies. Braz. J. Microbiol. Publ. Braz. Soc. Microbiol. 2021, 52, 1701–1718. [Google Scholar] [CrossRef]
- Muñoz-Egea, M.-C.; Akir, A.; Esteban, J. Mycobacterium biofilms. Biofilm 2023, 5, 100107. [Google Scholar] [CrossRef]
- Al-Ghafli, H.; Al-Hajoj, S. Nontuberculous Mycobacteria in Saudi Arabia and Gulf Countries: A Review. Can. Respir. J. 2017, 2017, 5035932. [Google Scholar] [CrossRef] [PubMed]
- WHO. Cancer facts 2022; WHO: Geneva, Switzerland, 2022. [Google Scholar]
- Smolarz, B.; Nowak, A.Z.; Romanowicz, H. Breast Cancer—Epidemiology, Classification, Pathogenesis and Treatment (Review of Literature). Cancers 2022, 14, 2569. [Google Scholar] [CrossRef]
- Bray, F.; Laversanne, M.; Sung, H.; Ferlay, J.; Siegel, R.L.; Soerjomataram, I.; Jemal, A. Global cancer statistics 2022: GLOBOCAN estimates of incidence and mortality worldwide for 36 cancers in 185 countries. CA Cancer J. Clin. 2024, 74, 229–263. [Google Scholar] [CrossRef] [PubMed]
- Voss, A.K.; Strasser, A. The essentials of developmental apoptosis. F1000Research 2020, 9, F1000 Faculty Rev-148. [Google Scholar] [CrossRef] [PubMed]
- Yusuf, K.; Sampath, V.; Umar, S. Bacterial Infections and Cancer: Exploring This Association And Its Implications for Cancer Patients. Int. J. Mol. Sci. 2023, 24, 3110. [Google Scholar] [CrossRef] [PubMed]
- Mir, M.A.; Bashir, N.; Alfaify, A.; Oteef, M.D.Y. GC-MS analysis of Myrtus communis extract and its antibacterial activity against Gram-positive bacteria. BMC Complement. Med. Ther. 2020, 20, 86. [Google Scholar] [CrossRef] [PubMed]
- Bhunu, B.; Mautsa, R.; Mukanganyama, S. Inhibition of biofilm formation in Mycobacterium smegmatis by Parinari curatellifolia leaf extracts. BMC Complement. Altern. Med. 2017, 17, 285. [Google Scholar] [CrossRef] [PubMed]
- Chaachouay, N.; Zidane, L. Plant-Derived Natural Products: A Source for Drug Discovery and Development. Drugs Drug Candidates 2024, 3, 184–207. [Google Scholar] [CrossRef]
- Zanetti, S.; Cannas, S.; Molicotti, P.; Bua, A.; Cubeddu, M.; Porcedda, S.; Marongiu, B.; Sechi, L.A. Evaluation of the Antimicrobial Properties of the Essential Oil of Myrtus communis L. against Clinical Strains of Mycobacterium spp. Interdiscip. Perspect. Infect. Dis. 2010, 2010, 931530. [Google Scholar] [CrossRef]
- Alyousef, A.A.; Mabood Husain, F.; Arshad, M.; Rizwan Ahamad, S.; Shavez Khan, M.; Abul Qais, F.; Khan, A.; Alqasim, A.; Almutairi, N.; Ahmad, I.; et al. Myrtus communis and its bioactive phytoconstituent, linalool, interferes with Quorum sensing regulated virulence functions and biofilm of uropathogenic bacteria: In vitro and in silico insights. J. King Saud Univ. Sci. 2021, 33, 101588. [Google Scholar] [CrossRef]
- Caputo, L.; Capozzolo, F.; Amato, G.; De Feo, V.; Fratianni, F.; Vivenzio, G.; Nazzaro, F. Chemical composition, antibiofilm, cytotoxic, and anti-acetylcholinesterase activities of Myrtus communis L. leaves essential oil. BMC Complement. Med. Ther. 2022, 22, 142. [Google Scholar] [CrossRef] [PubMed]
- Hoch, C.C.; Petry, J.; Griesbaum, L.; Weiser, T.; Werner, K.; Ploch, M.; Verschoor, A.; Multhoff, G.; Bashiri Dezfouli, A.; Wollenberg, B. 1,8-cineole (eucalyptol): A versatile phytochemical with therapeutic applications across multiple diseases. Biomed. Pharmacother. 2023, 167, 115467. [Google Scholar] [CrossRef] [PubMed]
- Kocaçalişkan, I.; Talan, I.; Terzi, I. Antimicrobial activity of catechol and pyrogallol as allelochemicals. Z. Naturforschung C J. Biosci. 2006, 61, 639–642. [Google Scholar] [CrossRef] [PubMed]
- Li, L.; Shi, C.; Yin, Z.; Jia, R.; Peng, L.; Kang, S.; Li, Z. Antibacterial activity of α-terpineol may induce morphostructural alterations in Escherichia coli. Braz. J. Microbiol. 2014, 45, 1409–1413. [Google Scholar] [CrossRef]
- Moo, C.-L.; Osman, M.A.; Yang, S.-K.; Yap, W.-S.; Ismail, S.; Lim, S.-H.-E.; Chong, C.-M.; Lai, K.-S. Antimicrobial activity and mode of action of 1,8-cineol against carbapenemase-producing Klebsiella pneumoniae. Sci. Rep. 2021, 11, 20824. [Google Scholar] [CrossRef] [PubMed]
- Trombetta, D.; Castelli, F.; Sarpietro, M.G.; Venuti, V.; Cristani, M.; Daniele, C.; Saija, A.; Mazzanti, G.; Bisignano, G. Mechanisms of Antibacterial Action of Three Monoterpenes. Antimicrob. Agents Chemother. 2005, 49, 2474–2478. [Google Scholar] [CrossRef]
- Polyudova, T.; Eroshenko, D.; Pimenova, E. The biofilm formation of nontuberculous mycobacteria and its inhibition by essential oils. Int. J. Mycobacteriology 2021, 10, 43. [Google Scholar] [CrossRef]
- Sarangi, A.; Das, B.S.; Rout, S.S.; Sahoo, A.; Gir, S.; Bhattacharya, D. Antimycobacterial and antibiofilm activity of garlic essential oil using vapor phase techniques. J. Appl. Biol. Biotechnol. 2022, 11. [Google Scholar] [CrossRef]
- Ehrhardt, H.; Wachter, F.; Grunert, M.; Jeremias, I. Cell cycle-arrested tumor cells exhibit increased sensitivity towards TRAIL-induced apoptosis. Cell Death Dis. 2013, 4, e661. [Google Scholar] [CrossRef]
- Alon-Maimon, T.; Mandelboim, O.; Bachrach, G. Fusobacterium nucleatum and cancer. Periodontol. 2000 2022, 89, 166–180. [Google Scholar] [CrossRef]
- Salvatori, S.; Marafini, I.; Laudisi, F.; Monteleone, G.; Stolfi, C. Helicobacter pylori and Gastric Cancer: Pathogenetic Mechanisms. Int. J. Mol. Sci. 2023, 24, 2895. [Google Scholar] [CrossRef]
- Qin, Y.; Chen, Y.; Chen, J.; Xu, K.; Xu, F.; Shi, J. The relationship between previous pulmonary tuberculosis and risk of lung cancer in the future. Infect. Agent. Cancer 2022, 17, 20. [Google Scholar] [CrossRef] [PubMed]
- PA, W. CLSI. Performance Standards for Susceptibility Testing of Mycobacteria, Nocardia spp., and Other Aerobic Actinomycetes. In Clinical Laboratory Standards Institute; supplement M62; Clinical Laboratory Standards Institute: Wayne, PA, USA, 2018; Volume 38, p. 17. ISBN 978-1-68440-027-0. ISBN 978-1-68440-028-7 (elctronic). [Google Scholar]
- Mir, M.; Altuhami, S.; Mondal, S.; Bashir, N.; Dera, A.; Alfhili, M. Antibacterial and Antibiofilm Activities of β-Lapachone by Modulating the Catalase Enzyme. Antibiotics 2023, 12, 576. [Google Scholar] [CrossRef] [PubMed]
- Kong, C.; Chee, C.-F.; Richter, K.; Thomas, N.; Abd Rahman, N.; Nathan, S. Suppression of Staphylococcus aureus biofilm formation and virulence by a benzimidazole derivative, UM-C162. Sci. Rep. 2018, 8, 2758. [Google Scholar] [CrossRef] [PubMed]
- Christensen, G.D.; Simpson, W.A.; Younger, J.J.; Baddour, L.M.; Barrett, F.F.; Melton, D.M.; Beachey, E.H. Adherence of coagulase-negative staphylococci to plastic tissue culture plates: A quantitative model for the adherence of staphylococci to medical devices. J. Clin. Microbiol. 1985, 22. [Google Scholar] [CrossRef] [PubMed]
- Alahdal, A.; Asfour, H.; Ahmed, S.; Noor, A.; Al-Abd, A.; Elfaky, M.; Elhady, S. Anti-Helicobacter, Antitubercular and Cytotoxic Activities of Scalaranes from the Red Sea Sponge Hyrtios erectus. Molecules 2018, 23, 978. [Google Scholar] [CrossRef]
- Shati, A.A.; Alkahtani, M.A.; Alfaifi, M.Y.; Elbehairi, S.E.I.; Elsaid, F.G.; Prasanna, R.; Mir, M.A. Secondary Metabolites of Saussurea costus Leaf Extract Induce Apoptosis in Breast, Liver, and Colon Cancer Cells by Caspase-3-Dependent Intrinsic Pathway. BioMed Res. Int. 2020, 2020, 1608942. [Google Scholar] [CrossRef]

| Origin | Organism | Zone of Inhibition Mean ± SD (mm) | MIC (μg/mL) | MBC (μg/mL) |
|---|---|---|---|---|
| SGM | M. avium ATCC25291 | 25.1 ± 4.1 | 19.53 | 156.2 |
| M. kansasii | 20.3 ± 1.1 | 9.768 | 78.14 | |
| M. kansasii ATCC35775 | 25.6 ± 3.2 | 4.884 | 39.07 | |
| M. xenopi | 20.5 ± 2.6 | 19.53 | 156.2 | |
| RGM | M. abscessus | 20.6 ± 3.2 | 39.07 | 312.5 |
| M. fortuitum ATCC6841 | 24.3 ± 3.7 | 156.2 | 937.2 | |
| M. mucogenicum | 22.6 ± 3.5 | 9.768 | 156.2 | |
| MTB | M. tuberculosis ATCC25177 | 26.3 ± 2.5 | 78.14 | 625 |
| M. tuberculosis RIF-R | 22.6 ± 2.5 | 312.5 | 1250 |
| Antibiotics | Zone Diameter (mm) in Alone | Zone Diameter (mm) in Combination with M. communis Leaf Extract |
|---|---|---|
| Vancomycin | 20 ± 1 | 26 ± 0 |
| Colistin | 16 ± 1 | 25 ± 2 |
| Bacitracin | 16 ± 1 | 21 ± 0 |
| Polymyxin | 25 ± 0 | 25 ± 0 |
| Chloramphenicol | 15 ± 2 | 24 ± 1 |
| Gentamycin | 35 ± 2 | 24 ± 1 |
| Clarithromycin | 31 ± 1 | 26 ± 2 |
| Ofloxacin | 35 ± 2 | 24 ± 0 |
| Tetracycline | 45 ± 2 | 35 ± 1 |
| Tumor Cell Line | IC50 (µg/mL) | Tumor Cell Line | IC50 (µg/mL) |
|---|---|---|---|
| MCF-7 | 41.5 ± 0.6 | HCT116 | 83 ± 2.5 |
| HepG2 | 53.3 ± 0.6 | HeLa | 33.3 ± 3.6 |
| Cancer Cell | Extracts | Cell Phases | ||
|---|---|---|---|---|
| G1 | S | G2/M | ||
| MCF-7 | Control | 49.92 ± 0.74 | 22.75 ± 0.8 | 27.33 ± 0.7 |
| Treated | 57.33 ± 0.9 | 12.09 ± 1.2 | 30.58 ± 0.81 | |
| HepG2 | Control | 54.23 ± 0.93 | 23.06 ± 2.01 | 22.71 ± 1.7 |
| Treated | 70.52 ± 0.79 | 12.15 ± 1.02 | 17.33 ± 0.75 | |
| HCT116 | Control | 52.13 ± 1.52 | 22.75 ± 0.98 | 25.12 ± 0.75 |
| Treated | 62.22 ± 0.78 | 10.38 ± 0.58 | 27.4 ± 2.02 | |
| HeLa | Control | 53.69 ± 0.87 | 17.09 ± 0.98 | 29.22 ± 1.02 |
| Treated | 65.35 ± 1.35 | 7.25 ± 0.94 | 27.4 ± 1.31 | |
Disclaimer/Publisher’s Note: The statements, opinions and data contained in all publications are solely those of the individual author(s) and contributor(s) and not of MDPI and/or the editor(s). MDPI and/or the editor(s) disclaim responsibility for any injury to people or property resulting from any ideas, methods, instructions or products referred to in the content. |
© 2024 by the authors. Licensee MDPI, Basel, Switzerland. This article is an open access article distributed under the terms and conditions of the Creative Commons Attribution (CC BY) license (https://creativecommons.org/licenses/by/4.0/).
Share and Cite
Mir, M.A.; Memish, L.A.; Elbehairi, S.E.; Bashir, N.; Masoud, F.S.; Shati, A.A.; Alfaifi, M.Y.; Alamri, A.M.; Alkahtani, S.A.; Ahmad, I. Antimycobacterial and Anticancer Properties of Myrtus communis Leaf Extract. Pharmaceuticals 2024, 17, 872. https://doi.org/10.3390/ph17070872
Mir MA, Memish LA, Elbehairi SE, Bashir N, Masoud FS, Shati AA, Alfaifi MY, Alamri AM, Alkahtani SA, Ahmad I. Antimycobacterial and Anticancer Properties of Myrtus communis Leaf Extract. Pharmaceuticals. 2024; 17(7):872. https://doi.org/10.3390/ph17070872
Chicago/Turabian StyleMir, Mushtaq Ahmad, Lamis Ahmad Memish, Serag Eldin Elbehairi, Nasreena Bashir, Faris Saif Masoud, Ali A. Shati, Mohammad Y. Alfaifi, Ahmad M. Alamri, Sultan Ahmad Alkahtani, and Irfan Ahmad. 2024. "Antimycobacterial and Anticancer Properties of Myrtus communis Leaf Extract" Pharmaceuticals 17, no. 7: 872. https://doi.org/10.3390/ph17070872
APA StyleMir, M. A., Memish, L. A., Elbehairi, S. E., Bashir, N., Masoud, F. S., Shati, A. A., Alfaifi, M. Y., Alamri, A. M., Alkahtani, S. A., & Ahmad, I. (2024). Antimycobacterial and Anticancer Properties of Myrtus communis Leaf Extract. Pharmaceuticals, 17(7), 872. https://doi.org/10.3390/ph17070872

